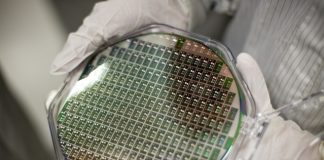
تجارب ألمانيّة لاستخلاص الجرمانيوم من النباتات

مجلة إلكترونية تهتم بأخبار وشؤون البيئة والتنمية وتضم أخباراً يومية ومقالات مختارة من وسائل الإعلام، ودراسات وقضايا تتعلق بالتغيرات المناخية والتقنيات الخضراء (الصديقة للبيئة) والطاقات المتجددة، وترصد نشاطات الجمعيات الأهلية والمؤسسات الحكومية العاملة على حماية البيئة، كما تسعى لتقديم مواد تعليمية تفاعلية لرفع الوعي لدى الجمهور بأهمية البيئة كوسط يجب المحافظة عليه وحمايته من الكوارث.